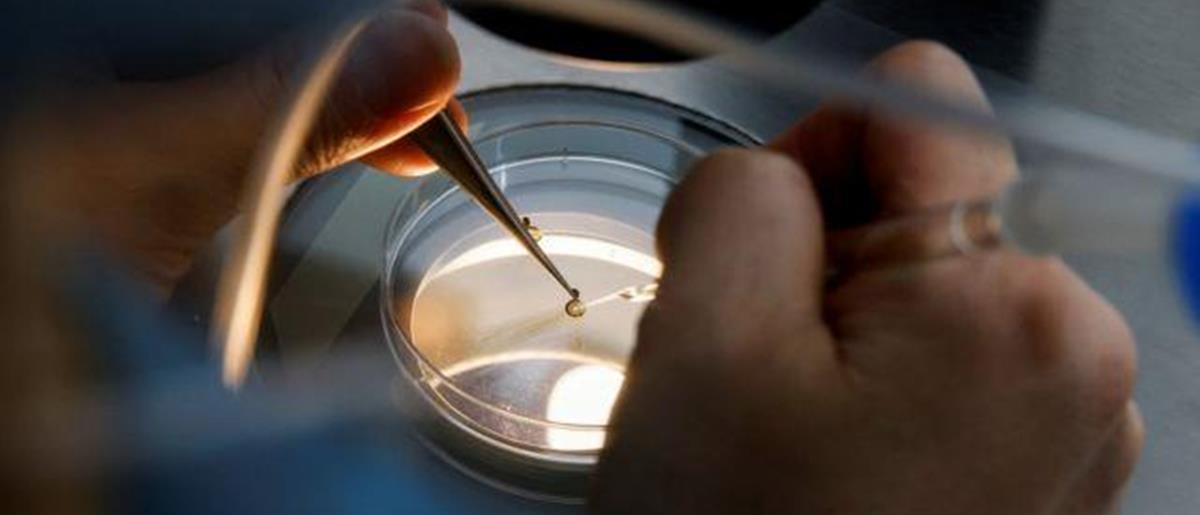
4228008780072961 1500

ΔΙΕΘΝΗ
ΔΙΕΘΝΗΣυστάσεις CDC για εμβολιασμό ομάδων εργαζομένων για την Ευλογιά των Πιθήκων
Ύποπτο κρούσμα της νόσου εντοπίστηκε στις ΗΠΑ
23:01 - 27 Μαΐου 2022
 ΔΙΕΘΝΗ
ΔΙΕΘΝΗΎποπτο κρούσμα της νόσου εντοπίστηκε στις ΗΠΑ
23:01 - 27 Μαΐου 2022
 ΤΟΠΙΚΕΣ ΕΙΔΗΣΕΙΣ
ΤΟΠΙΚΕΣ ΕΙΔΗΣΕΙΣΣυνολικά 219 κρούσματα σε όλο τον κόσμο μέχρι και την 25η Μαΐου
09:57 - 27 Μαΐου 2022
ΔΙΕΘΝΗ
ΔΙΕΘΝΗΔεν έχουν σημειωθεί θάνατοι αναφέρει το ECDC
12:42 - 26 Μαΐου 2022
 ΤΟΠΙΚΕΣ ΕΙΔΗΣΕΙΣ
ΤΟΠΙΚΕΣ ΕΙΔΗΣΕΙΣΗ Επιτροπή Εμβολιασμού συζητά την αναγκαιότητα εμβολιασμού σε ορισμένες κατηγορίες πληθυσμού
11:41 - 26 Μαΐου 2022
 ΔΙΕΘΝΗ
ΔΙΕΘΝΗΟ λόγος που προκάλεσε την έξαρση της νόσου
22:45 - 24 Μαΐου 2022
 ΕΛΛΑΔΑ
ΕΛΛΑΔΑΟι συστάσεις της Εθνικής Επιτροπής Εμβολιασμών
21:27 - 24 Μαΐου 2022
 ΔΙΕΘΝΗ
ΔΙΕΘΝΗΜετά το Βέλγιο καραντίνα και στη Γερμανία για τα κρούσματα
21:06 - 24 Μαΐου 2022
 ΔΙΕΘΝΗ
ΔΙΕΘΝΗ«Απίθανο ο ιός να έχει μεταλλαχθεί»
13:22 - 24 Μαΐου 2022
 ΔΙΕΘΝΗ
ΔΙΕΘΝΗΠρόκειται για άνδρα
11:45 - 24 Μαΐου 2022